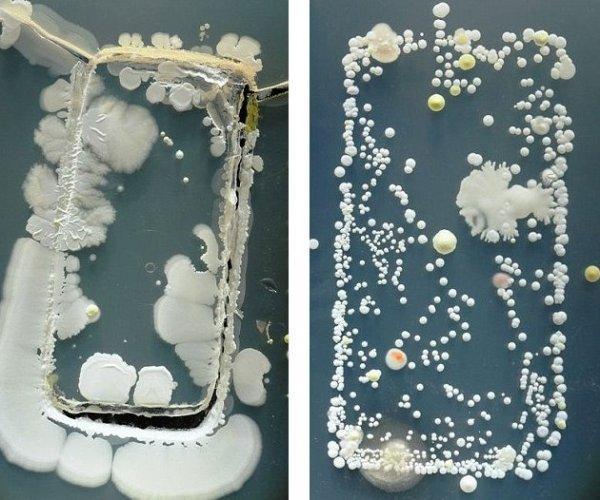
手机竟比马桶还脏

手机竟比马桶还脏
手机竟比马桶还脏:最近几天朋友圈又在谈这个话题,其实,早在大屏幕智能手机还没流行的时候,就有媒体报道过相关新闻,除了手机外,键盘、水龙头等等都被曝光过比马桶脏。专家称,不用害怕,手机上的细菌对人的危害不大。

手机竟比马桶还脏
英国的的研发人员增做过测试:他们在不同的手机上各安装了一些常用APP,然后模拟我们平时使用手机的状况。6个小时之后用化妆棉擦拭并检测,结果每片化妆棉上至少有600个的金黄色葡萄菌。
吓人!手机上的细菌比马桶的还多
网上传言,我们常用手机的细菌量为每平方厘米12万个之多,请注意这是每平方厘米的细菌载量数据,如此推算的话整部手机携带的细菌总量保守计算都在100万以上,而这个数量级足以使马桶圈和马桶垫上的细菌队伍甘拜下风了。那么手机脏了该怎么办呢?
在最近热传的帖子里,有一组培养皿中菌落的图片,分别来自不同的几部手机和马桶。测试显示,经过第一个24小时,大部分的培养皿中都长出了小如针尖、大如小米的菌落,但一部经常被擦拭的手机培养皿中与之前并无区别,看似非常干净。但在第二个24小时过后,之前看似干净的培养皿中也未能幸免,同样长出了很多肉眼可见的菌落,而之前针尖大小的菌落变成了米粒大小。在经过了第三个24小时,送检的每一个培养皿中都长出了不同颜色以及大小清晰的菌落,最大的有硬币大小。
不少网友表示“受到了惊吓”,但更多的网友关注的是,手机真的有这么脏吗?
手机脏还是马桶脏:对比没什么意义
这则传言真的靠谱吗?紫金山记者就此问题采访了南京市第一医院感染科陶臻主任。
“我觉得这种文章只是吸引人眼球。”陶臻主任表示,他也看过类似的卫生机构做的测试,也是经过两三天的细菌培养,结果显示手机上的细菌数量比马桶高。这是因为马桶经常冲,很多人用手机并不会经常擦拭。
陶臻主任认为这种对比并没什么意义,因为检测结果只显示细菌数量,并没有显示这是什么类型的细菌,“如果单纯只显示细菌数量和形状,那我们的体表比如手上、脚上取一块皮层,放培养皿中两三天时间,菌落长出来也是五花八门,放大看也很吓人的。”
另外,此前还有检测显示马桶的细菌比手机多。陶臻主任表示,这可能和选取检测的部位不同有关系,比如选取的是家用马桶还是公共卫生间里的马桶、是马桶盖还是马桶圈还是马桶内壁、是什么职业的人用的手机等等这些都可能影响检测结果,因此对比手机和马桶培养出来的细菌数没有意义。
手机细菌致病风险低,但某些职业要注意
既然对比没什么意义,那为什么“手机比马桶脏”的传言会一年又一年的传得火热呢?陶臻主任表示,可能因为显微镜下的细菌形状太吓人。要说明的是,大多数情况下,手机上的细菌几乎是无害的,就像我们的双手一样,通常都会携带不同数量和种类的各种细菌,但对我们的身体健康不会造成危害。
不过,陶臻主任提醒,有些职业工作者的手机要注意,可能会有致病菌。“比如我们医生、护士,在医院这个环境工作,手机上长出来的菌落很可能是医院环境里的细菌长出来的,致病菌的几率会大很多。”因此,医生一般会经常会擦拭手机,尤其是下班回家前。
此外,陶臻主任表示,虽然有的测试显示手机的细菌比马桶细菌多,但是比致病细菌的话,还是马桶比较多,“家用马桶还好,公共卫生间的马桶、医院的马桶等等,致病几率比手机大得多。”
手机清洁有没有必要?适当即可不要过
记者在网上搜索发现,不少商家也以类似推文为广告,推出手机清洗液,还有一些微信文章建议大家用消毒制品如玻璃清洗剂、酒精等擦拭手机,称这样可以有效减少手机上的细菌。这些方法可以用吗?
“擦拭手机的话,用普通湿纸巾或眼镜布就可以了。”陶臻主任表示,和人脸的皮肤一样,一天洗两三次就够了,不能总洗,手机也是适当清洁就好,无需经常清洁。首先普通细菌并不会对人体造成危害,其次一些清洗液并不能有效清除手机上的致病菌反而会对手机屏幕造成损伤。
陶臻主任说,除了擦拭外,在我们日常使用手机的过程中,勤洗手可以减少细菌通过手附着在手机上的几率。还要注意不要将手机带到卫生间,防止卫生间的细菌附着在手机上。
另外,现在不少人喜欢在手机上装个手机壳,既漂亮又防摔,陶臻主任表示,因为手机壳和手机间有缝隙,细菌更容易长时间附着,因此如果要用手机壳,一定要注意边边缝缝的清洁。
本文“”来源:http://www.lkttc.com/keji/xw/70423.html,转载必须保留网址。







